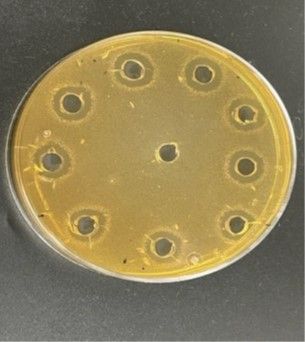
El CTNC lidera un proyecto de investigación para sustituir aditivos químicos alimentarios por bioconservantes - 1, Foto 1

El Centro Tecnológico Nacional de la Conserva y Alimentación (CTNC) lidera un proyecto de investigación cuyo objetivo es sustituir aditivos de síntesis química por bioconservantes, garantizando la seguridad alimentaria en productos cárnicos.
El proyecto denominado 'Caracterización y optimización de la producción de bioconservantes mediante el uso de fermentadores' bajo el acrónimo ET5BIOPERSEV, estudia el uso de bacteriocinas como conservantes alimentarios de origen natural.
"Las bactericionas son péptidos, producidos por múltiples bacterias, que presentan la ventaja de no tener efectos nocivos para el ser humano", tal y como explicó José Fernández, responsable del laboratorio de Microbiología y Seguridad Alimentaria del CTNC, quien añadió que "con este trabajo, pretendemos buscar microorganismos productores de bacteriocinas en diferentes fuentes naturales para que puedan ser empleadas en la industria alimentaria".
Una vez aislados dichos microorganismos, se utilizarán biorreactores para optimizar el crecimiento y producción de estos metabolitos de interés. En una última etapa se evaluará su efectividad aplicándolas sobre distintos tipos de alimentos, fundamentalmente cárnicos.
Cabe señalar que debido al rechazo, por parte del consumidor, a los aditivos químicos alimentarios de origen sintético y los beneficios que aportan los alimentos "naturales" y "tradicionales", la industria alimentaria se enfrenta a desafíos que incluyen la demanda de productos alimenticios que no contengan conservantes químicos, libres de microorganismos patógenos y con un vida útil más extensa. En este caso, afirmó Fernández, "las bacteriocinas son una opción atractiva como parte de la solución a estos problemas".